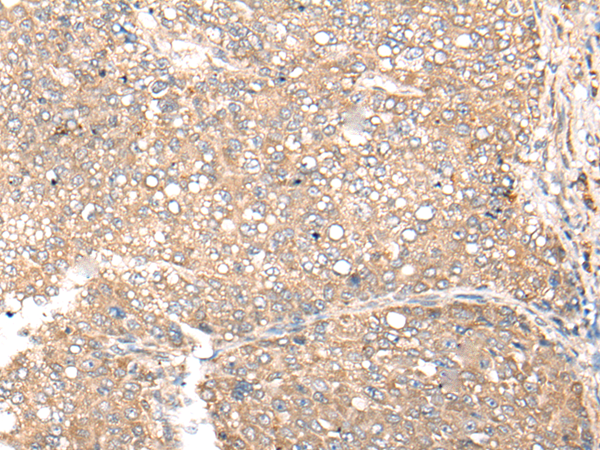

中文名稱:兔抗CDC123多克隆抗體
英文名稱: Anti-CDC123 rabbit polyclonal antibody
別 名: D123; C10orf7
相關類別: 一抗
儲 存: 冷凍(-20℃)
宿 主: Rabbit
反應種屬: Human, Mouse, Rat
標 記 物: Unconjugate
克隆類型: rabbit polyclonal
技術規格
|
Background: |
The eukaryotic cell division cycle consists of a number of gene-controlled sequences that involve cyclin dependent kinases (Cdks) and cell division control (Cdc) proteins. Cdc123 (Cell division cycle protein 123), also known as D123, is a 336 amino acid cytoplasmic protein that is involved in cell cycle control. Widely expressed with high expression in thymus, spleen, ovary, testis, small intestine and leukocytes, Cdc123 functions to destabilize Chfr (checkpoint with forkhead and ring finger domain) proteins which, when accumulated, block the G to S phase transition. Cdc123 prevents the Chfr proteins from collecting in the cell, thereby allowing the cell to enter the S phase. Due to its role in cell cycle control, Cdc123 is thought to be a basal marker for luminal breast cancers. |
|
Applications: |
ELISA, IHC |
|
Name of antibody: |
CDC123 |
|
Immunogen: |
Synthetic peptide of human CDC123 |
|
Full name: |
cell division cycle 123 |
|
Synonyms: |
D123; C10orf7 |
|
SwissProt: |
O75794 |
|
ELISA Recommended dilution: |
5000-10000 |
|
IHC positive control: |
Human liver cancer |
|
IHC Recommend dilution: |
25-100 |
購物車
購物車 幫助
幫助
 021-54845833/15800441009
021-54845833/15800441009
